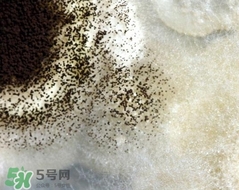
諾如病毒會反復(fù)感染嗎?諾如病毒會再次感染嗎?

歡迎您,來到5號網(wǎng)!
時間:2017-03-08 15:18:38 編輯:5號網(wǎng)-pmm 7733
諾如病毒是常見的兒童疾病,有些媽媽覺得孩子已經(jīng)得過一次了,后面就不用再注意了。那么諾如病毒會反復(fù)感染嗎?諾如病毒會再次感染嗎?
諾如病毒遺傳高度變異,在同一時期和同一社區(qū)內(nèi)可能存在遺傳特性不同的毒株流行。諾如病毒抗體沒有顯著的保護(hù)作用,尤其是沒有長期免疫保護(hù)作用,極易造成反復(fù)感染。感染諾如病毒后最常見的癥狀是腹瀉、嘔吐、惡心,或伴有發(fā)熱、頭痛等癥狀。兒童患者嘔吐、惡心多見,成人患者以腹瀉為多,嘔吐少見。病程一般為2-3天,此病是一種自限性疾病,恢復(fù)后無后遺癥。
1、感染能力強。10~100個病毒顆粒就能引起感染,這個量其實非常小,大概只相當(dāng)于百分之一滴飛沫。
2、傳播迅速,容易暴發(fā)。由于與流感病毒相似,所以也被稱為胃腸性流感。
3、容易變異?;蚨鄻?,每隔數(shù)年就會出現(xiàn)變異的新型病毒,人的防御系統(tǒng)就不認(rèn)識它,以前產(chǎn)生的抵抗手段會失效,所以人一生中可多次感染,每次都要制造新武器來消滅病毒。
4、一般都能自愈。感染后,多數(shù)不用抗病毒治療,靠人的免疫功能就能自愈。一般情況下對癥治療就可以,例如補水、退熱、保護(hù)胃腸道粘膜等。

1、諾如病毒容易出現(xiàn)變異,在同一時期和同一社區(qū)內(nèi)可能存在幾種不同類型的諾如病毒流行。
2、生命力和耐受性較強,經(jīng)過室溫環(huán)境中暴露仍然具有傳染性,普通消毒劑不能完全殺死病毒,殺滅病毒,需要煮沸消毒至少15~20分鐘才能。

3、人感染諾如病毒后產(chǎn)生的抗體,沒有長期免疫保護(hù)的能力;同時這些抗體對其他變異的新型病毒并沒有抵抗保護(hù)作用,極易造成諾如病毒反復(fù)感染。
相關(guān)文章
熱門文章
5H跟帖
最熱標(biāo)簽
精選文章
美容養(yǎng)生醫(yī)療母嬰
猜你喜歡
網(wǎng)站簡介|網(wǎng)絡(luò)營銷|法律聲明|友情鏈接|聯(lián)系我們|意見反饋
Copyright ? 2012 - 2015 5h.com All Rights Reserved 5號健康網(wǎng)版權(quán)所有 鄂ICP備15005143號-3
提示:本站信息僅供參考,不能作為診斷及醫(yī)療的依據(jù);請謹(jǐn)慎參閱,本站不承擔(dān)由此引起的法律責(zé)任。本網(wǎng)站敬告網(wǎng)民:身體若有不適,請及時到醫(yī)院就診。
所有文章來自互聯(lián)網(wǎng) 如有異議 請與本站聯(lián)系 本站為非贏利性網(wǎng)站 不接受任何贊助和廣告
網(wǎng)友評論僅供其表達(dá)個人看法,并不表明5h立場。